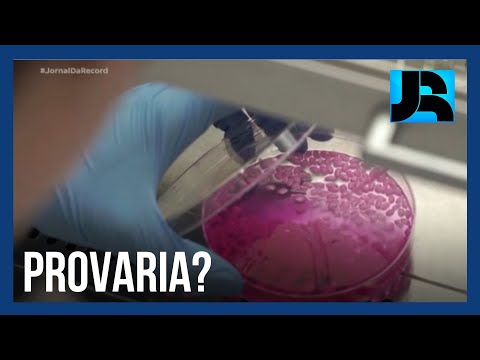

Selecione o dia...
sexta-feira, 29 de março de 2024
quinta-feira, 28 de março de 2024
quarta-feira, 27 de março de 2024
terça-feira, 26 de março de 2024
segunda-feira, 25 de março de 2024
domingo, 24 de março de 2024
sexta-feira, 22 de março de 2024
Assinar:
Comentários (Atom)